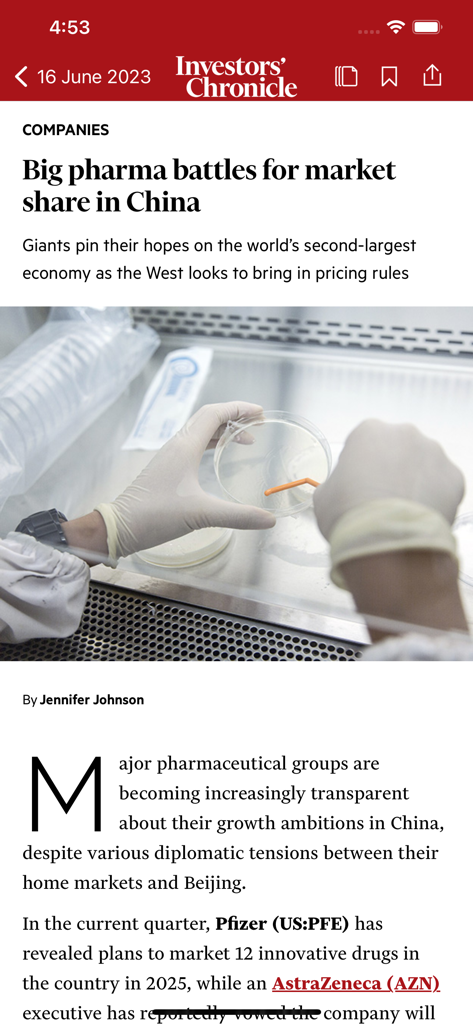
Investors Chronicle - Una interfaz móvil que muestra un artículo de análisis financiero sobre empresas farmacéuticas en la aplicación Investors Chronicle.

Esta página no es una página oficial de la aplicación ni de su desarrollador, sino una publicación editorial independiente creada con fines informativos y de comentario. Salvo que se indique expresamente lo contrario, ni la aplicación ni su desarrollador están afiliados, respaldados, patrocinados, autorizados ni conectados oficialmente con MWM, Apple, Google Play, el editor de la aplicación ni su desarrollador, y nada en esta página implica que la aplicación haya sido desarrollada utilizando los servicios de MWM. Todas las marcas comerciales, logotipos, capturas de pantalla y demás contenidos son propiedad de sus respectivos propietarios.
Investors Chronicle
Aprovecha más de 155 años de experiencia financiera. Únete a los inversores privados más sofisticados del mundo cada viernes para obtener consejos detallados sobre acciones, investigación de fondos y el análisis global que necesitas para mantenerte a la vanguardia del mercado.
Descargas
103K+Valoración
Total valoraciones
4K+Editor
Categoría
FinanceIdiomas
1Última versión
20.3Tamaño
20.8 MBFecha de lanzamiento
2 abr 2013Invierte con Confianza Absoluta
Accede a inteligencia líder en el mercado y análisis autorizados diseñados para ayudar al inversor privado serio a superar al mercado.
Recomendaciones para Superar el Mercado
Descubre consejos de acciones y fondos de alta convicción cada viernes, respaldados por la rigurosa investigación fundamental de los expertos del Financial Times.
Cobertura Exhaustiva de Empresas
Navega por el mercado con análisis detallados de más de 1.000 empresas anualmente, proporcionándote los datos necesarios para tomar decisiones sofisticadas.
Apps Similares
Apps con características y experiencia similares

DailyArt
Zuzanna Stanska
Apps Gone Free & Daily Tips
App Advice

New Scientist
NEW SCIENTIST LIMITED

三联中读-让阅读更高品质
Sanlian Shenghuo Media Co., Ltd
The Intercooler – Car Magazine
DriveNation Media Ltd

Architectural Digest
Advance Magazine Publishers Inc.

Scientific American
Springer Nature America, Inc.

Good Housekeeping UK
Hearst Communications, Incorporated

House & Garden
The Conde Nast Publications Limited
Esta página no es una página oficial de la aplicación ni de su desarrollador, sino una publicación editorial independiente creada con fines informativos y de comentario. Salvo que se indique expresamente lo contrario, ni la aplicación ni su desarrollador están afiliados, respaldados, patrocinados, autorizados ni conectados oficialmente con MWM, Apple, Google Play, el editor de la aplicación ni su desarrollador, y nada en esta página implica que la aplicación haya sido desarrollada utilizando los servicios de MWM. Todas las marcas comerciales, logotipos, capturas de pantalla y demás contenidos son propiedad de sus respectivos propietarios.